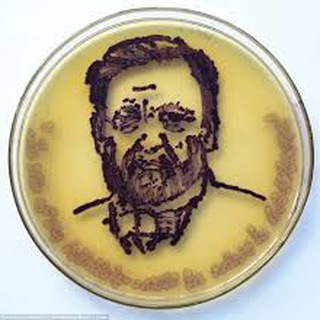

مسابقه عكاسي http://blogs.biomedcentral.com/bmcblog/2017/07/10/bmc-research-in-progress-photo-competition-now-open-submissions/
Research in progress blog
BMC “Research in Progress” photo competition now open for submissions - Research in progress blog
Have you heard? BioMed Central is becoming BMC. At BMC, we believe our research communities share our enthusiasm for innovation, science and progress, and we would like to see it from your perspective – so we are launching our first ever “Research in Progress”…